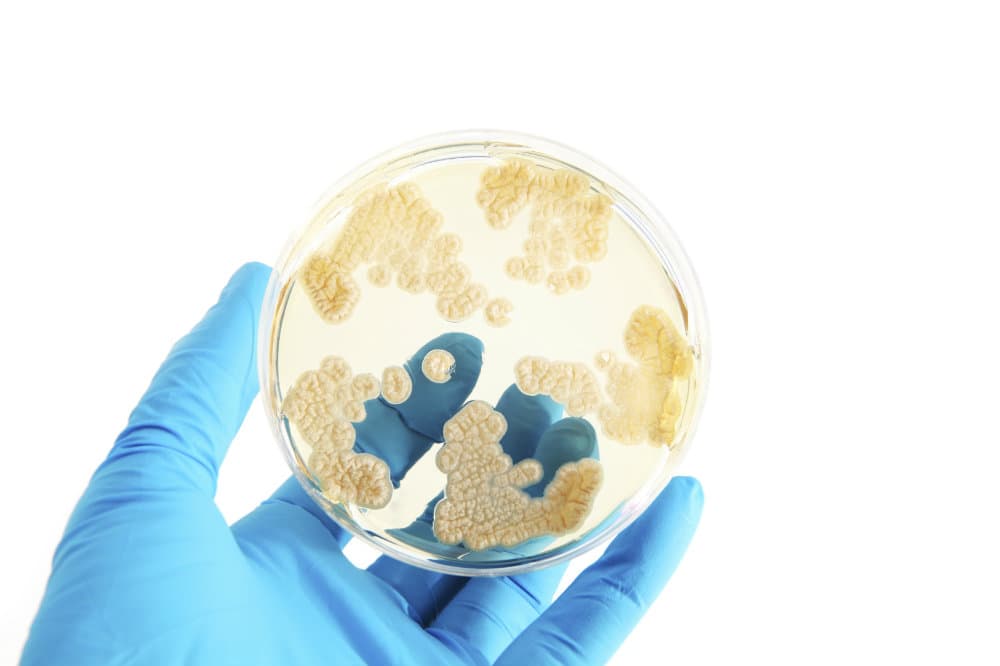
Cómo evitar los antibióticos

Medicamentos
Medicamentos: Últimas noticias, videos y fotos de Medicamentos
Pros y contras de los ansiolíticos
En el mercado, existe una variada oferta de ansiolíticos. A corto plazo, estos medicamentos pueden resultar muy efectivos en el tratamiento de la ansiedad. Ahora bien, si vamos a consumirlos, es fundamental conocer también sus efectos secundarios. En este artículo, te facilitaremos esta información y te mostraremos los pros y los contras de los ansiolíticos.
LO MÁS RECIENTE

Síntomas de alergia a los medicamentos
Muchas personas no saben que los remedios pueden ocasionar alergias; es un pensamiento lógico si partimos de la base de que se utilizan para sanar, sus efectos aparecen de forma inmediata o también luego de varios días de haberlo tomado. Por eso te presentamos 6 síntomas de alergia a los medicamentos que debes conocer.

Los peligros de medicarse durante el embarazo
Tomar medicamentos para un tratamiento durante o justo antes del embarazo puede provocar perturbaciones a nivel del desarrollo del embrión o del feto. Estar embarazada supone respetar ciertas reglas para evitar cualquier tipo de accidente. Conozcamos los peligros de medicarse durante el embarazo a continuación.

5 riesgos de tomar píldoras de estrógenos
Puede que estés medicada con sustancias que no sepas que riesgos conllevan. Aunque debemos confiar en los profesionales, nunca está demás saber qué es lo que estamos tomando y los efectos secundarios que puede ocasionarnos. Por eso hoy te contamos 5 riesgos de tomar píldoras de estrógenos.

¿Con qué tipo de líquidos debemos tomar los medicamentos?
Sucede que muchas veces nos tomamos el medicamento y este no parecer tener efecto cuando se trata de aliviar el dolor. De inmediato culpamos al médico por la dosis, al medicamento por la calidad o enviamos un par de culpas internas que hablan del intenso dolor difícil de curar. Sin embargo, puede que la responsabilidad no sea el medicamento en sí, sino otras razones. Mira cuáles.

Los métodos anticonceptivos femeninos
Cuando se tiene una vida sexual activa se debería pensar junto con la pareja cuál podría ser el mejor método anticonceptivo para prevenir embarazos no deseados. Para elegir el método hay que tener en cuenta factores como la edad, la frecuencia de la actividad sexual, los deseos de tener un hijo en el futuro e incluso los antecedentes familiares. Sigue leyendo para conocer más acerca de la anticoncepción.

¿Una cura definitiva para la artritis reumatoide?
Para un médico puede ser difícil responder la siguiente pregunta: ¿cura definitiva para la artritis reumatoide? Y no decimos que sea difícil por el diagnostico, en realidad decirle a una persona que aún no existe una cura para su enfermedad puede ser complejo. Sin embargo, un buen médico hará lo posible para que la calidad de vida de su paciente sea la indicada y pueda convivir con su enfermedad. Hoy te contaremos cómo.